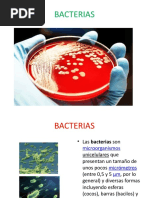
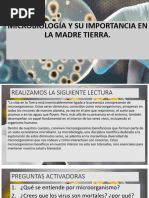

0% encontró este documento útil (0 votos)
91 vistas7 páginasCaracterísticas y Clasificación de las Bacterias
El documento describe el reino Monera, que incluye a los organismos procariotas divididos en bacterias y cianobacterias. Las bacterias son los monera más abundantes y se encuentran en casi cualquier ambiente, variando en tamaño, forma y funciones. Se reproducen de forma asexual por bipartición. Los microbiólogos estudian bacterias, virus y otros microorganismos para comprenderlos y aplicar ese conocimiento en áreas como la medicina y la industria alimentaria. Louis Pasteur fue un pionero fundador de la microbiología moderna a través de sus descubrim
Cargado por
Perseo RellDerechos de autor
© © All Rights Reserved
Nos tomamos en serio los derechos de los contenidos. Si sospechas que se trata de tu contenido, reclámalo aquí.
Formatos disponibles
Descarga como PDF, TXT o lee en línea desde Scribd
0% encontró este documento útil (0 votos)
91 vistas7 páginasCaracterísticas y Clasificación de las Bacterias
El documento describe el reino Monera, que incluye a los organismos procariotas divididos en bacterias y cianobacterias. Las bacterias son los monera más abundantes y se encuentran en casi cualquier ambiente, variando en tamaño, forma y funciones. Se reproducen de forma asexual por bipartición. Los microbiólogos estudian bacterias, virus y otros microorganismos para comprenderlos y aplicar ese conocimiento en áreas como la medicina y la industria alimentaria. Louis Pasteur fue un pionero fundador de la microbiología moderna a través de sus descubrim
Cargado por
Perseo RellDerechos de autor
© © All Rights Reserved
Nos tomamos en serio los derechos de los contenidos. Si sospechas que se trata de tu contenido, reclámalo aquí.
Formatos disponibles
Descarga como PDF, TXT o lee en línea desde Scribd